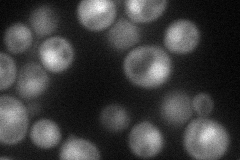
YPL148C
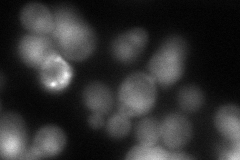
YPL148C
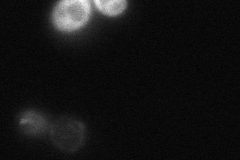
YPL148C
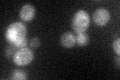
YPL148C

View description
Phosphopantetheine:protein transferase (PPTase), activates mitochondrial acyl carrier protein (Acp1p) by phosphopantetheinylation
Localization:
Intensity:
Fold change:
Significance:
-
C’ GFP library in SD

below threshold17.61 -
N' NOP1pr-GFP in SD
cytosol,nucleus58.0758 -
N' TEF2pr-mCherry in SD
cytosol,nucleus97.0189 -
N' NATIVEpr-GFP in SD
punctate20.5716 -
N' TEF2pr-VC and Cyto-VN in SD

below threshold20.3231 -
C’ GFP library in SD+DTT
cytosolN/AN/ANo -
C’ GFP library in SD+H2O2

cytosolN/AN/ANo -
C’ GFP library in Starvation Media

cytosolN/AN/AYes -
C’ GFP library on the background of Pup2-DaMP

below threshold -
C’ GFP library on the background of CCT mutant

below thresholdN/AN/ANo
